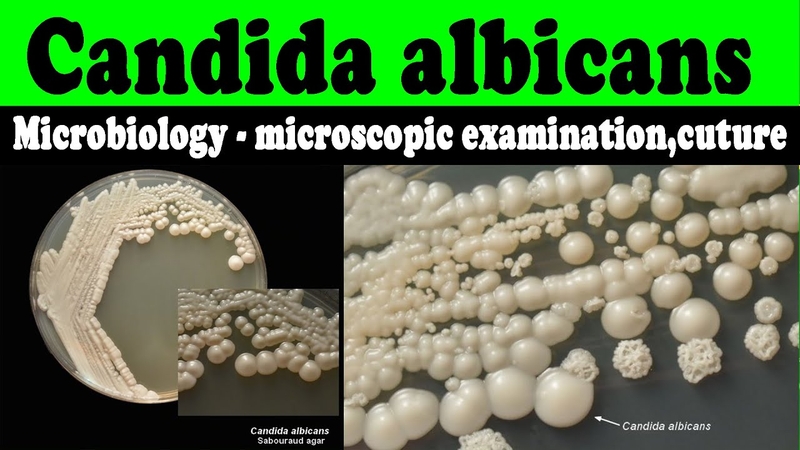
Nấm miệng có nguy hiểm không 1

Tốt nghiệp đại học Khoa Dược. Có kinh nghiệm hơn 10 năm trong lĩnh vực Dược phẩm, tư vấn thuốc và thực phẩm chức năng. Hiện đang là giảng viên cho Dược sĩ tại Nhà thuốc Long Châu.
Nấm miệng có nguy hiểm không?
21/06/2023
Mặc định
Lớn hơn
Nấm miệng là một trong số những bệnh thường gặp ở trẻ sơ sinh, trẻ nhỏ, và những người suy giảm miễn dịch. Vậy bệnh nấm miệng có nguy hiểm không? Bệnh có thể thoái lui nhanh, không gây nguy hiểm gì nhưng cũng có thể diễn biến nặng nề nếu người bệnh không điều trị đúng và kịp thời.
Việt Nam là một trong những nước tỉ lệ nhiễm các bệnh về nấm cao trên thế giới. Lứa tuổi mắc bệnh hoàn toàn không giới hạn, và điều nhiều người lo lắng là: "Nấm miệng có nguy hiểm không? Có gây hậu quả gì nghiêm trọng không?". Ở bài viết này, Nhà Thuốc Long Châu sẽ cùng các bạn giải đáp tất cả những thắc mắc đó bạn nhé!
Nấm miệng là gì?
Nấm miệng là tình trạng tổn thương niêm mạc miệng, lưỡi, má do sự phát triển quá mức của nấm Candida albicans gây nên. Bình thường nấm Candida luôn tồn tại trên bề mặt da, niêm mạc cơ thể như miệng, hầu họng, âm đạo… mà không gây bệnh nhờ sự kìm hãm của hệ miễn dịch của cơ thể. Khi sức đề kháng suy giảm, loại nấm này mới phát triển biểu hiện thành bệnh nấm miệng.
Hình ảnh nấm Candida - Nguyên nhân gây nấm miệng
Hình ảnh nấm Candida - Nguyên nhân gây nấm miệngNhững dấu hiệu nhận biết bệnh nấm miệng
Nhiễm nấm miệng biểu hiện rất đa dạng, đôi khi không gây triệu chứng gì nhưng khi tình trạng nhiễm trùng lan rộng, các triệu chứng sau sẽ xuất hiện:
- Nấm miệng nhẹ thường chỉ biểu hiện với tổn thương màu kem trắng, màu vàng gây mùi hôi, ngứa ngáy trong khoang miệng, đôi khi trên vòm miệng, amidan, nướu, lợi, khi cạo hoặc cọ xát, tổn thương có thể chảy máu.
- Nấm miệng lâu ngày làm nứt niêm mạc miệng, nứt khóe miệng.
- Ở trẻ sơ sinh, trẻ còn bú mẹ: Trẻ quấy khóc khi bú do đau, nặng thì có bỏ bú, trẻ có thể làm mẹ cùng bị nhiễm nấm do quá trình bú. Mẹ sẽ biểu hiện bệnh chủ yếu ở ngực, núm vú với triệu chứng sau: Núm vú sưng nề, đỏ, chảy dịch, nứt đầu ti, rất đau và ngứa.
- Khi không kịp thời xử lý, nấm miệng sẽ lan xuống thực quản với biểu hiện: Khó nuốt, nuốt vướng, cảm giác nghẹn, đôi khi gây ợ hơi, ợ chua, buồn nôn, cảm giác nóng rát ở cổ, ngực. Nặng hơn nữa, nấm đi đến làm tổn thương các cơ quan nội tạng ở sâu hơn, rồi đi vào máu làm nhiễm nấm máu.
Nấm miệng có đau không?
Giai đoạn đầu, triệu chứng nhẹ, nấm miệng có thể không gây đau hay khó chịu gì cho người bệnh. Tuy nhiên khi không điều trị đúng, tổn thương sẽ gây đau rát do làm sưng nề, nứt niêm mạc. Với trẻ nhỏ, miệng bị nấm khiến trẻ khó chịu hoặc quấy khóc khi bú, đôi khi làm trẻ bỏ bú. Người lớn, nấm miệng làm đau nhức hoặc rát trong miệng, gây khó khăn khi ăn hoặc nuốt.
 Nấm miệng có thể gây đau ở giai đoạn cấp khi nấm sinh sôi mạnh
Nấm miệng có thể gây đau ở giai đoạn cấp khi nấm sinh sôi mạnhNấm miệng có nguy hiểm không?
Nhiễm nấm miệng thường nhẹ và ít gây vấn đề nghiêm trọng. Tuy nhiên, nó phụ thuộc vào sức đề kháng của cơ thể. Nó hiếm khi là một vấn đề đối với trẻ nhỏ và người lớn khỏe mạnh, dù sự lây nhiễm có thể tái nhiễm trở lại. Nhưng đối với những người bị tổn thương hệ thống miễn dịch, nấm miệng nguy hiểm hơn nhiều. Vậy những đối tượng như thế nào nấm miệng có nguy cơ tiến triển? Đó là những người có yếu tố nguy cơ như sau:
- Người mắc bệnh suy giảm miễn dịch như HIV, người già suy giảm sức đề kháng, người bệnh đang phải sử dụng các thuốc ức chế miễn dịch…
- Người bệnh ung thư, đang điều trị bằng hóa trị hoặc xạ trị.
- Bệnh nhân tiểu đường kiểm soát tốt đường huyết không tốt.
- Người mắc các bệnh mạn tính phải sử dụng thuốc corticoid đường hít như hen phế quản, bệnh phổi tắc nghẽn mạn tính, người phải dùng corticoid đường uống liều cao kéo dài: Hội chứng thận hư, bệnh hệ thống,...
- Người đeo răng giả, mà không vệ sinh răng miệng thường xuyên, đúng cách.
- Người hút nhiều thuốc lá nhiều.
Những đối tượng trên nấm dễ lan xuống làm tổn thương ở sâu hơn gây biến chứng nặng nề như: Nấm thực quản, viêm nội tâm mạc, viêm màng não, hay nhiễm nấm Candida máu làm nấm lan đi khắp các cơ quan trong cơ thể, có thể gây tử vong.
Khi bị nấm miệng nên ăn gì và không nên ăn gì?
Nấm miệng nên ăn gì?
Nhiễm nấm gây ra sự đau đớn và khó chịu khi ăn uống, sinh hoạt. Vì vậy, hãy lựa chọn loại thức phẩm thông minh có thể làm cải thiện nhanh tình trạng. Dưới đây là một số thức ăn thích hợp cho người mắc bệnh:
- Sữa chua: Sữa chua chứa một lượng lợi khuẩn dồi dào, giúp cân bằng hệ vi sinh trong khoang miệng, nhờ vậy kìm hãm và giảm bớt sự phát triển của nấm. Hơn nữa, sữa chua mềm rất phù hợp người bệnh bị khó nuốt, khi ăn, nhai.
- Nước chanh: Có pH acid nên có tính sát khuẩn nhẹ. Nên với 1 thìa nước cốt chanh hòa vào nước ấm để súc miệng hàng ngày hoặc uống thường xuyên sẽ giúp cải thiện nấm miệng.
- Vitamin C: Bổ sung vitamin C là biện pháp hữu hiệu giúp nâng cao hệ miễn dịch cơ thể, chống lại sự phát triển của nấm Candida. Ở Việt Nam có rất nhiều thực phẩm giàu vitamin C như ổi, cam, các loại quả có vị chua, các loại rau xanh như rau ngót, rau cải,...
 Dinh dưỡng cũng là yếu tố cần được nhắc tới khi điều trị nấm miệng
Dinh dưỡng cũng là yếu tố cần được nhắc tới khi điều trị nấm miệngNấm miệng không nên ăn gì?
Bên cạnh đó, có những loại thức ăn người nhiễm nấm nên tránh sử dụng:
- Thức ăn cay nóng: Càng làm tăng tổn thương niêm mạc do nấm, các vết loét sẽ sâu hơn, nghiêm trọng hơn. Đồ ăn cay nóng còn làm người bệnh khó ăn, khó nuốt, cơ thể không được cung cấp đầy đủ dinh dưỡng. Vì vậy, người bệnh nên ăn thức ăn để nguội, không quá nóng, tránh các thức ăn cay như ớt, tương ớt, hạt tiêu, mù tạt,…
- Chất kích thích có chứa trong nhiều sản phẩm: Thuốc lá, cà phê, nước có ga, rượu, bia… Các sản phẩm này có thể gây ra sự mất cân bằng vi sinh của cơ thể và hệ tiêu hóa và làm nấm Candida càng phát triển mạnh mẽ.
- Đường chính là nguồn thức ăn ưa thích của loài nấm khuẩn Candida. Khi ăn quá nhiều tinh bột như cơm, bánh mì, đồ ngọt, đồ lên men,... chúng sẽ được enzym amylase ở nước bọt phân giải nhanh chóng thành nhiều đường glucose, tạo môi trường cung cấp dinh dưỡng cho loại nấm men này sinh sản và phát triển nhiều hơn.
- Nấm miệng thông thường dường như không mang lại khó chịu, nguy hiểm nhiều cho người mắc, nhưng không nên vì thế mà chủ quan lơ là trong việc điều trị bệnh. Khi có các biểu hiện của nấm miệng, chúng ta nên đến cơ sở y tế để được chẩn đoán đúng và tìm được nguyên nhân gây bệnh để điều trị hiệu quả và nhanh nhất.
Bên cạnh bổ sung thức ăn dinh dưỡng, chúng ta cũng nên vệ sinh răng miệng sạch sẽ thường xuyên, đánh răng ít nhất 2 lần/ngày, súc miệng bằng nước súc miệng có tính kháng khuẩn hoặc nước muối sau khi ăn để tạo một khoang miệng sạch, không cho nấm phát triển thêm.
Với bài viết trên đây, Nhà thuốc Long Châu hi vọng đã mang những thông tin hữu ích tới quý độc giả về bệnh nấm miệng có nguy hiểm không, từ đó giúp bạn và người thân có cách chăm sóc và ăn uống phù hợp khi bị nấm miệng nhé!
Vũ Ánh
Nguồn tham khảo: Tổng hợp
Có thể bạn quan tâm
Các bài viết liên quan
Hình ảnh nấm lưỡi ở người lớn dễ nhận biết và cách xử lý an toàn
Chữa nấm da ở trẻ sơ sinh như thế nào là đúng cách?
Bị nấm da đầu có gây rụng tóc không?
Thuốc trị nấm ngoài da cho bà bầu có an toàn không?
Nấm hậu môn do nguyên nhân nào? Những điều bạn cần biết
Nhiễm nấm Candida ở nam giới có nguy hiểm không? Cách phòng nấm Candida ở nam giới
Đặc điểm cấu tạo của nấm gây bệnh trên người
Nguyên nhân bị nấm da đầu và cách điều trị hiệu quả
Lớp màng nhầy màu trắng bên trong miệng phát sinh do đâu?
Cách chữa hắc lào nhanh khỏi nhất
:format(webp)/Option_1_2_2d9677e5fd.png)
:format(webp)/Option_1_1_2a84e0cd00.png)
:format(webp)/smalls/6g_Nree_Hb_QDPN_Ev6_Hb_Bi_O_Fbtfj_Requ_H_a6c447b975.png)